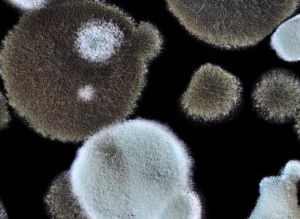
霉菌感染

霉菌感染
霉菌感染是指绒毛在基质上生长、有棉絮或蜘蛛网菌丝体的真菌。霉菌是“丝状真菌”的统称。任何在基质上长绒毛的东西、带有棉絮或蜘蛛网菌丝体的真菌称为霉菌。
霉菌在分类上属于子囊菌、藻状菌与半知菌。传统酿酒用的是霉菌、除了制作酱油和其他发酵食品外,近年来在发酵工业中被广泛用于生产酒精、柠檬酸、青霉素、灰黄霉素、赤霉素、淀粉酶、发酵饲料等。
形态结构 编辑本段
霉菌细胞都是由分枝或不分枝的菌丝组成,许多菌丝交织在一起,称为菌丝体。菌丝体平均直径2 ~ 10a,比一般细菌和放线菌大几倍到几十倍,与酵母相似。霉菌营养菌丝图)霉菌的菌落特征:霉菌的菌落由分枝的菌丝组成。因为菌丝又粗又长,形成的菌落松散蓬松、棉絮或蜘蛛网,一般比细菌菌落大几倍到几十倍。起初,菌落通常是浅色或白色的当各种颜色的孢子在菌落上生长时,孢子具有不同的形状、结构和色素,菌落表面常出现肉眼可见的不同结构和颜色,如黄色、绿、青、黑、橙、蓝等各色。有些霉菌在培养基的正反面呈现不同的颜色是因为产生的色素可以扩散到培养基中,所以菌落特征也是鉴别霉菌的主要依据之一。
霉菌的繁殖方式有很多种,主要是形成无性孢子和有性孢子。一般霉菌的菌丝体生长到一定阶段,首先无性繁殖,后期在同一菌丝体上产生有性生殖结构,形成有性孢子。与人类生活和食品生产密切相关的霉菌包括藻菌纲的根霉、毛霉、犁霉;子囊菌属红曲霉;曲霉和青霉等。毛霉广泛应用于食品工业例如,大毛霉可以产生单羟基丁酮、脂肪酶。鲁氏毛霉不仅用于酿酒工业,还用于制作豆腐乳,总状毛霉用于制作豆豉。一些毛霉也可以用来转化类固醇产生草酸、乳酸、琥珀酸以及甘油。根霉经常出现在淀粉类食物上,引起食物霉变变质。它能把淀粉转化成糖,所以是我们国家、朝鲜、东南亚使用的日本清酒曲或日本清酒曲的主要糖化细菌。逍遥曲在中国s省、根霉是民间甜酒曲中的主要菌种。
曲霉是一种发酵工业、医药工业、食品工业中的重要菌株。在中国,曲霉菌被用来制作酱油,酱油被人们用来酿酒、醋曲制作的主要菌种。现代工业使用曲霉,生产各种酶制剂(淀粉酶、蛋白酶、果胶酶等)有机酸(柠檬酸、葡萄糖酸等)在农业上可用作糖化饲料。有些曲霉菌会产生有害物质,如黄曲霉毒素。工业上常用黑曲霉、米曲霉和土曲霉。红曲用于制作红曲,至今仍是一种优良的天然食用色素,如红豆腐就是典型产品。还有一种红曲霉,能产生α-淀粉酶、麦芽糖酶等,用来水解淀粉,制造葡萄糖。近年来,它已被用于工业生产糖化酶制剂。
附件列表
词条内容仅供参考,如果您需要解决具体问题
(尤其在法律、医学等领域),建议您咨询相关领域专业人士。